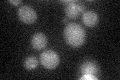
YDR452W
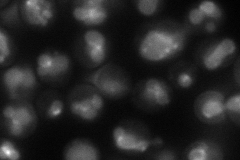
YDR452W
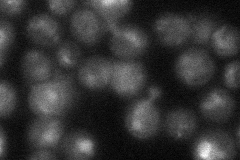
YDR452W

View description
Vacuolar endopolyphosphatase with a role in phosphate metabolism; functions as a homodimer
Localization:
Intensity:
Fold change:
Significance:
-
C’ GFP library in SD
cytosol21.02 -
N' NOP1pr-GFP in SD
vacuole79.1259 -
N' TEF2pr-mCherry in SD

vacuole156.016 -
N' NATIVEpr-GFP in SD
vacuole28.5979 -
N' TEF2pr-VC and Cyto-VN in SD

below threshold27.5915 -
C’ GFP library in SD+DTT

cytosol19.680.93No -
C’ GFP library in SD+H2O2

cytosol20.370.96No -
C’ GFP library in Starvation Media

cytosol17.730.84No -
C’ GFP library on the background of Pup2-DaMP

cytosol -
C’ GFP library on the background of CCT mutant

cytosol23.77271.13072No
